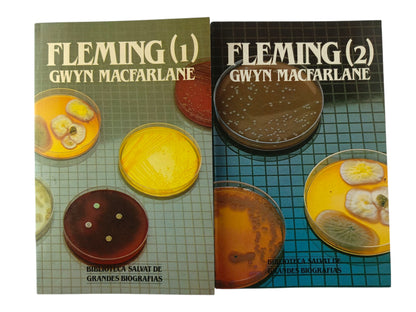
Fleming 2 tomos

Robert Gwyn Macfarlane
Fleming 2 tomos
Fleming 2 tomos
Precio habitual
$50.000
Precio habitual
Precio de oferta
$50.000
Precio unitario
/
por
Estado: Usado 8/10
Los gastos de envío se calculan en la pantalla de pago.
Característica:
Biografía
No se pudo cargar la disponibilidad de retiro
Share
Entre los grandes avances que registraron las ciencias médicas y biológicas en el siglo XIX cabe destacar el establecimiento del origen microbiano de las enfermedades infecciosas, que debemos a investigadores de la talla de Louis Pasteur y Robert Koch. Sin embargo, a pesar de los ingentes esfuerzos orientados al desarrollo de vacunas, muchas enfermedades infecciosas siguieron siendo mortales, pues se carecía de medios para combatirlas una vez contraídas. En este contexto se comprende la trascendencia del hallazgo de una sustancia, la penicilina, que era capaz de destruir los gérmenes patógenos sin dañar al organismo.
500 Páginas - Tapa blanda
Código: 1000008510
Ver todos los detalles